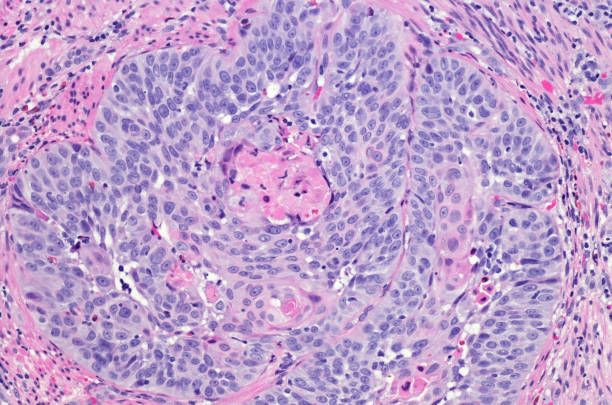
Плоскоклеточный рак фото начальная стадия Плоскоклеточный рак фото начальная стадия

Плоскоклеточное интраэпителиальное поражение низкой
Плоскоклеточное интраэпителиальное поражение низкой
Более 1 700 работ на тему "аденокарцинома": стоковые фото, картинки и изображени
Более 1 700 работ на тему "аденокарцинома": стоковые фото, картинки и изображени
 Плоскоклеточный рак кожи: причины возникновения и методы лечения
Плоскоклеточный рак кожи: причины возникновения и методы лечения
 Профилактика рака кожи
Профилактика рака кожи
 Datei:Squamous cell carcinoma 3.jpg - Wikipedia
Datei:Squamous cell carcinoma 3.jpg - Wikipedia
 Wart Removal Зображення - огляд 42,027 Стокові фото, векторні зображення й відео
Wart Removal Зображення - огляд 42,027 Стокові фото, векторні зображення й відео
 Ороговевающий плоскоклеточный рак - Olphoto.ru
Ороговевающий плоскоклеточный рак - Olphoto.ru
 Гистологическая картина плоскоклеточного рака
Гистологическая картина плоскоклеточного рака
 Рак кожи: симптомы, признаки, диагностика
Рак кожи: симптомы, признаки, диагностика
 File:Systematic microscopy 3 - Architectural pattern, original.jpg - Wikimedia C
File:Systematic microscopy 3 - Architectural pattern, original.jpg - Wikimedia C
 Предоперационная химиолучевая терапия рака шейки матки с включением тегафура (пр
Предоперационная химиолучевая терапия рака шейки матки с включением тегафура (пр
 Squamous cell, Esophageal cancer, Science and nature
Squamous cell, Esophageal cancer, Science and nature
 Плоскоклеточная неороговевающая карцинома: найдено 90 изображений
Плоскоклеточная неороговевающая карцинома: найдено 90 изображений
 Презентация на тему: ПЛОСКОКЛЕТОЧНЫЙ РАК
Презентация на тему: ПЛОСКОКЛЕТОЧНЫЙ РАК
 Презентация на тему: Фиброаденома молочной железы
Презентация на тему: Фиброаденома молочной железы
 Базалиома носа: поражения слизистой кожи, операция по удалению на начальной стад
Базалиома носа: поражения слизистой кожи, операция по удалению на начальной стад
 Cutaneous squamous-cell carcinoma - Wikipedia
Cutaneous squamous-cell carcinoma - Wikipedia
 Файл:Squamous cell carcinoma (medium differentiated).jpg - Вікіпедія
Файл:Squamous cell carcinoma (medium differentiated).jpg - Вікіпедія
 Причины развития плоскоклеточного рака кожи, провоцирующие его факторы - Медицин
Причины развития плоскоклеточного рака кожи, провоцирующие его факторы - Медицин
 Squamous cell carcinoma of the lung MyPathologyReport.ca
Squamous cell carcinoma of the lung MyPathologyReport.ca
 Skin Cancer #1 Photograph by Cnri/science Photo Library - Fine Art America
Skin Cancer #1 Photograph by Cnri/science Photo Library - Fine Art America
 Дифференцировки плоскоклеточного рака - найдено 87 картинок
Дифференцировки плоскоклеточного рака - найдено 87 картинок
 Плоскоклеточный рак лимфатического узла: найдено 90 картинок
Плоскоклеточный рак лимфатического узла: найдено 90 картинок
 Surplus of antioxidants increases probability of emergence of metastasises of a
Surplus of antioxidants increases probability of emergence of metastasises of a
 Лечение рака легких, услуги пульмонолога, отделение пульмонологии
Лечение рака легких, услуги пульмонолога, отделение пульмонологии
 Эпигенетический тест определил рак шейки матки на ранней стадии лучше, чем станд
Эпигенетический тест определил рак шейки матки на ранней стадии лучше, чем станд
 Гистологическая картина плоскоклеточного рака
Гистологическая картина плоскоклеточного рака
:max_bytes(150000):strip_icc()/microscopicpathsquamous-56a5c4cd3df78cf77289d794.jpg) Tumor Markers: Definition and Examples
Tumor Markers: Definition and Examples
 Плоскоклеточный рак легкого: прогноз (сколько живут), лечение в Израиле стоматол
Плоскоклеточный рак легкого: прогноз (сколько живут), лечение в Израиле стоматол
 Плоскоклеточный высокодифференцированный рак: Плоскоклеточный рак: высокодиффере
Плоскоклеточный высокодифференцированный рак: Плоскоклеточный рак: высокодиффере